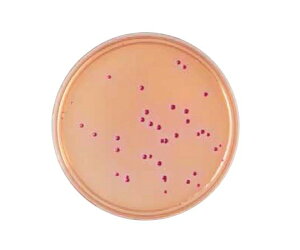
xNgEfBbL\ BD@BBLiTMj@f\LVR[gV|n 251550 1(1{×20)

- bd 50 (すべてのカテゴリ)
- DIY・工具
- 素材・補修材
- その他の素材・補修材
- 12ページ目
「bd 50」の人気商品一覧 | 安い商品を通販サイトから探す
2,660件 441〜480件を表示- 価格の安い順
- 価格の高い順
- 検索条件:
- その他の素材・補修材
- 本ページでは掲載するECサイトやメーカー等から購入実績などに基づいて手数料を受領しています。

その他の素材・補修材
BD発泡ウレタン 洗浄クリーナー 550ml缶 BD発泡ウレタン 750ml ノズル ガン タイプ 15本/箱 BD発泡ウレタン 340ml ノズルタイプ 24本/箱 発泡ウレタン ガン HT-GUN...

その他の素材・補修材
耐久性素材:高強度複合パネル製で、経年劣化や衝撃に耐えます。表面は特殊処理を施しており、日常的な衝撃やぶつかりにも損傷・ひび割れ・変形なく耐えられます。 細部までこだわった設計:カバープレートの角は丸みを帯びており、バリのない滑らかな...

その他の素材・補修材
【特長】●埋込四角アウトレットボックスに断熱材を接着した商品です。結露防止にもおすすめです。●ノック付きです。使用するノックを断熱カバーの上からハンマー等で打ち抜けば、コネクタが簡単に取り付けられます。

その他の素材・補修材
エスコ ジョイントナイフ(軟/ハンマーヘッド) 51×202mm EA579BD-50A 1本●刃材質:ハイカーボンスチール●ハンドル材質:樹脂製●全長:202mm●刃幅:51mm●刃長:90mm●刃厚:先端:約0.4mm、●腰の硬さ...

その他の素材・補修材
定格出力電圧[DC]5Vdc■出力電圧範囲[DC]4.5~5.5Vdc■最大出力電流10A■最大出力電力50W

その他の素材・補修材
【高品質素材】高品質のプラスチックで作り、頑丈で耐久性も高いです。掃除した後、繰り返して使えます。 初心者でも美しい道をつくることができます。 それは非常に簡単で、あなたはそれを試すことができます。 【繰り返して使用】あらゆる方向に連...

その他の素材・補修材
Welcome to my store!

その他の素材・補修材
●メーカー:イマオコーポレーション ●型式:CBD1-50 ●出荷目安:3営業日以内

その他の素材・補修材
ワークショップ、ガレージ、家の改善作業に最適です。 利点:屋内外での使用に適した超弾力性と靭性。 振動、変形、経年変化。 優れた遮音効果で、ノイズの伝達を効果的に低減します。 材質:高品質ゴム製。 高品質のゴム製で、重い負荷に耐え、摩...

その他の素材・補修材
【電気的特性】■入力単相■入力電圧範囲[AC]85~265Vac■出力電圧範囲[DC]120~370Vdc■効率86%■出力数1■定格出力電圧[DC]48Vdc■出力電圧範囲[DC]38.4~52.8Vdc■最大出力電流1.1A■最大...

その他の素材・補修材
セパレーター QTYH 大口径減圧バルブ QTY08-10-15-20-25-32-40-50 エアフィルター

その他の素材・補修材
六角対辺:8mm 【サイズ】 #250 穴径1.4mm M6×1.0 【入数】 1 EA300BD7...
この商品で絞り込む

その他の素材・補修材
ゴムサイズ(直径×高さ):40*30mm 40*40mm 50*20mm 50*25mm 50*30mm 50*40mm 50*50mm 60*40mm 60*50mm 70*40mm 75*40mm 75*55mm...

その他の素材・補修材
【電気的特性】■入力単相■入力電圧範囲[AC]85~264Vac■出力電圧範囲[DC]120~370Vdc■効率89.5%■出力数1■定格出力電圧[DC]24Vdc■出力電圧範囲[DC]21.6~28.5Vdc■最大出力電流2.1A■...

その他の素材・補修材
●内容量…50ml●完全硬化時間…60分(23℃)●使用温度範囲…10〜40℃●可使時間…3分(23℃)●耐熱温度…80℃まで●色…灰●2液型ウレタン接着剤●第4類第4石油類非水溶性●速乾タイプで肉盛り、研削可能●充填・硬化後約15分...

その他の素材・補修材
●内容量…50ml●完全硬化時間…60分(23℃)●使用温度範囲…10〜40℃●可使時間…3分(23℃)●耐熱温度…80℃まで●色…灰●2液型ウレタン接着剤●第4類第4石油類非水溶性●速乾タイプで肉盛り、研削可能●充填・硬化後約15分...

その他の素材・補修材
【電気的特性】■入力単相■入力電圧範囲[AC]85~265Vac■出力電圧範囲[DC]120~370Vdc■効率87%■出力数1■定格出力電圧[DC]24Vdc■出力電圧範囲[DC]19.2~28.8Vdc■最大出力電流2.2A■最大...

その他の素材・補修材
【電気的特性】■入力単相■入力電圧範囲[AC]85~265Vac■出力電圧範囲[DC]120~370Vdc■効率85%■出力数1■定格出力電圧[DC]12Vdc■出力電圧範囲[DC]9.6~14.4Vdc■最大出力電流4.3A■最大出...

その他の素材・補修材
【電気的特性】■入力単相■入力電圧範囲[AC]85~265Vac■出力電圧範囲[DC]120~370Vdc■効率78%■出力数1■定格出力電圧[DC]3.3Vdc■出力電圧範囲[DC]2.97~3.96Vdc■最大出力電流10A■最大...
この商品で絞り込む

その他の素材・補修材
●酵母、真菌および耐酸性微生物の培養用液体培地です。●粉末培地●局方対応●用途:酵母・真菌用●質量:500g
この商品で絞り込む
その他の素材・補修材
●グラム陰性菌用の選択分離培地です。■仕様●生培地●用途:食品検査用●入数:20枚入
この商品で絞り込む

その他の素材・補修材
ゴムサイズ(直径×高さ):40*30mm 40*40mm 50*20mm 50*25mm 50*30mm 50*40mm 50*50mm 60*40mm 60*50mm 70*40mm 75*40mm 75*55mm...

その他の素材・補修材
●メーカー:テクノ・ソテック ●型式:BD-0850 ●厚み:0.8mm ●幅:50mm ●長さ:10m ●出荷目安:5営業日以内

その他の素材・補修材
製品品番・BD-0850材質/特徴品名:ボスブラックテープ50mmx0.8mmx10M品番:BD-0850JANコード:4580055820502入数:1商品説明商品特徴:●厚み0.8mm×幅50mmのポリエチレン発泡材黒色両面テープ...

その他の素材・補修材
商品詳細 【インテリア商材・E-スタート発送商品】 ・メーカー直送商品とは同梱できません。 ・コンビニ受取り不可商品です。 ・代金引換ができません。 ・納品書や領収書などを同梱する事はできません。 ・注文・決済完了後、2日から4日

その他の素材・補修材
【電気的特性】■入力単相■入力電圧範囲[AC]85~265Vac■出力電圧範囲[DC]120~370Vdc■効率84%■出力数1■定格出力電圧[DC]3.3Vdc■出力電圧範囲[DC]2.97~3.63Vdc■最大出力電流10A■最大...

その他の素材・補修材
【電気的特性】■入力単相■入力電圧範囲[AC]85~265Vac■出力電圧範囲[DC]120~370Vdc■効率86%■出力数1■定格出力電圧[DC]12Vdc■出力電圧範囲[DC]10.8~13.2Vdc■最大出力電流4.3A■最大...

その他の素材・補修材
【電気的特性】■入力単相■入力電圧範囲[AC]85~132Vac■出力電圧範囲[DC]~Vdc■効率85%■出力数1■定格出力電圧[DC]15Vdc■出力電圧範囲[DC]13.5~16.5Vdc■最大出力電流3.5A■最大出力電力52.5W

その他の素材・補修材
●メーカー:ダイドレ ●型式:T3B-DK 50 ●呼び(mm):50 ●ねじ基準径d:59.614 ●出荷目安:5営業日以内

その他の素材・補修材
【電気的特性】■入力単相■入力電圧範囲[AC]85~265Vac■出力電圧範囲[DC]~Vdc■効率88%■出力数1■定格出力電圧[DC]48Vdc■出力電圧範囲[DC]48~48Vdc■最大出力電流1.25A■最大出力電力60W

その他の素材・補修材
【電気的特性】■入力単相■入力電圧範囲[AC]85~132Vac■出力電圧範囲[DC]~Vdc■効率85%■出力数1■定格出力電圧[DC]12Vdc■出力電圧範囲[DC]12~12Vdc■最大出力電流4.3A■最大出力電力51.6W

その他の素材・補修材
【電気的特性】■入力単相■入力電圧範囲[AC]85~265Vac■出力電圧範囲[DC]80~370Vdc■効率86%■出力数1■定格出力電圧[DC]15Vdc■出力電圧範囲[DC]12~18Vdc■最大出力電流3.5A■最大出力電力5...

その他の素材・補修材
●メーカー:ダイドレ ●型式:T5B-DSH-PC 50 ●呼び(mm):50 ●ねじ基準径d:59.614 ●出荷目安:5営業日以内

その他の素材・補修材
●メーカー:アウス ●型式:D-5NI-40-50L※ ●φD:87.1 ●備考:標準長さスリーブ ●出荷目安:3営業日以内

その他の素材・補修材
コンパクト設計でスペース節約 高精度な制御が可能 長寿命設計 簡単なインストール 多様な流体に対応

その他の素材・補修材
●メーカー:エスコ ●型式:EA615BD-11 ●梱包サイズ(mm):203×17×60 ●出荷目安:3営業日以内

その他の素材・補修材
耐久性素材:高強度複合パネル製で、経年劣化や衝撃に耐えます。表面は特殊処理を施しており、日常的な衝撃やぶつかりにも損傷・ひび割れ・変形なく耐えられます。 細部までこだわった設計:カバープレートの角は丸みを帯びており、バリのない滑らかな...
その他の素材・補修材カテゴリで検索されているキーワード:
お探しの商品はみつかりましたか?
検索条件の変更
ご利用前にお読み下さい
- ※ ご購入の前には必ずショップで最新情報をご確認下さい
- ※ 「掲載情報のご利用にあたって」を必ずご確認ください
- ※ 掲載している価格やスペック・付属品・画像など全ての情報は、万全の保証をいたしかねます。あらかじめご了承ください。
- ※ 各ショップの価格や在庫状況は常に変動しています。購入を検討する場合は、最新の情報を必ずご確認下さい。
- ※ ご購入の前には必ずショップのWebサイトで価格・利用規定等をご確認下さい。
- ※ 掲載しているスペック情報は万全な保証をいたしかねます。実際に購入を検討する場合は、必ず各メーカーへご確認ください。
- ※ ご購入の前にネット通販の注意点をご一読ください。
- ※ 本ページでは掲載するECサイトやメーカー等から購入実績などに基づいて手数料を受領しています。
- bd 50
- DIY・工具
- 素材・補修材
- その他の素材・補修材の通販情報・価格比較
- 価格.com
© Kakaku.com, Inc. All Rights Reserved. 無断転載禁止





